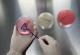

|  |
 2025.12.26(금) 22:04 2025.12.26(금) 22:04 |
|
||
 |
| 시사 | 광주광역시 | 전라남도 | 전라북도 | 제주도 | 특집기획 | 오피니언 | 커뮤니티 |
 |
제호 : 시사종합신문|등록번호 : 광주, 아00535|등록연월일 : 2011.03.16|발행/편집인/대표이사 : 오승택|청소년보호책임자 : 오승택
광주본부 ㉾ 61924 광주광역시 서구 양동 264-12, 1층|전화 (062)524-1600|전남본부 ㉾ 57942 전라남도 순천시 성동2길 24(동외동)|전화 (061)746-2222
전북본부 ㉾ 54801 전북특별자치도 전주시 덕진구 번영로 263(성덕동)|전화 (063)214-4300|기사제보 : sisatotal@hanmail.net
제주본부 ㉾ 63008 제주특별자치도 제주시 한경면 고산로 87(고산리)|전화 010-2080-6002
[주식회사 시사종합신문]를 통해 제공되는 모든 콘텐츠(기사 및 사진)는 무단사용, 복사, 배포시 저작권법에 저해되며 법적 제재를 받을수 있습니다. | ||